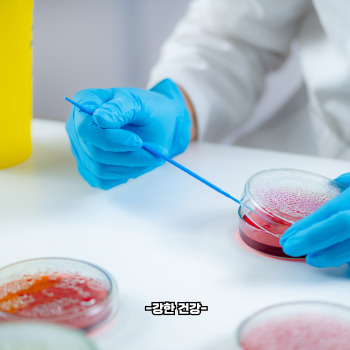
혈뇨가 나오는 이유

혈뇨가 나오는 이유 : 방광염 전립선 비대증 방광암

소변에서 피가 비친다는 것은 누구에게나 큰 충격으로 다가옵니다. 평소와 달리 붉은빛이 감도는 소변을 보는 순간, 많은 분들이 심각한 질환을 떠올리며 불안에 휩싸이게 되지요. 하지만 혈뇨는 원인에 따라 단순한 염증일 수도 있고, 심각한 신장·방광 질환의 신호일 수도 있습니다.
혈뇨는 단순히 “소변에 피가 섞인 상태”를 의미하지만, 그 원인은 다양합니다. 겉으로 드러나는 증상은 같아도 내부적으로는 전혀 다른 기전이 숨어 있기 때문에, 반드시 정확한 진단이 필요합니다. 오늘은 혈뇨란 무엇인지, 그리고 발생할 수 있는 대표적인 이유 7가지를 구체적으로 살펴보겠습니다.
혈뇨란? 🌿
혈뇨(Hematuria)는 소변에 적혈구가 섞여 나오는 상태를 말합니다. 눈으로 확인할 수 있을 정도로 붉거나 갈색을 띠는 경우를 ‘육안적 혈뇨’라 하고, 현미경 검사에서만 적혈구가 보이는 경우는 ‘현미경적 혈뇨’라고 부릅니다.
대한비뇨의학회 자료에 따르면, 성인의 약 10~20%는 일생에 한 번 이상 혈뇨를 경험한다고 합니다. 그러나 그 원인은 단순 요로 감염부터 신장암, 방광암에 이르기까지 매우 다양하기 때문에, 혈뇨가 반복되거나 원인 불명으로 나타난다면 반드시 검사를 받아야 합니다.
혈뇨가 나오는 이유 7가지 🚨
1) 요로감염(방광염, 신우신염) 🦠

혈뇨의 가장 흔한 원인은 요로감염입니다. 특히 여성의 경우 방광염이 흔하게 발생하며, 이때 소변 시 통증, 잦은 배뇨와 함께 혈뇨가 동반될 수 있습니다. 감염으로 인해 방광 점막이나 요도 점막이 손상되면서 소변에 피가 섞여 나오는 것이지요.
『New England Journal of Medicine』에 실린 연구에서는 급성 방광염 환자의 30% 이상에서 육안적 혈뇨가 동반된다는 보고가 있습니다. 치료는 주로 항생제를 사용하며, 수분 섭취를 늘려 세균을 빠르게 배출하는 것이 중요합니다.
2) 요로결석(신장결석, 요관결석) 💎
결석은 신장이나 요관, 방광에 돌처럼 굳은 덩어리가 생기는 질환입니다. 결석이 요로를 지나가며 점막을 긁으면 출혈이 발생해 혈뇨가 나타납니다. 동시에 옆구리 심한 통증, 구역질, 잦은 배뇨가 동반되기도 합니다.
『Journal of Urology』 연구에 따르면 요로결석 환자의 약 85%가 현미경적 혈뇨를 경험한다고 합니다. 결석이 작은 경우 수분 섭취와 약물 치료로 배출을 시도할 수 있고, 큰 경우 체외충격파쇄석술(ESWL)이나 내시경 수술이 필요합니다.
3) 전립선 질환(비대증, 전립선염, 전립선암) 🩺




남성에게 혈뇨가 나타날 때 전립선 질환도 주요 원인입니다. 전립선이 커져 요도를 압박하거나, 염증으로 인해 혈관이 손상되면 소변에 피가 섞여 나올 수 있습니다. 특히 전립선암은 초기 증상이 뚜렷하지 않다가 혈뇨로 발견되는 경우도 많습니다.
대한비뇨기과학회 보고에 따르면, 전립선비대증 환자의 약 15%가 혈뇨를 경험한다고 합니다. 이는 단순한 노화 현상이 아니라 전립선 비대가 방광 내 혈관 압력을 높이면서 생기는 결과이므로 반드시 검사가 필요합니다.
4) 신장 질환(사구체신염, 신장암) 🧬
신장은 혈액을 걸러 노폐물을 소변으로 배출하는 역할을 합니다. 신장 자체에 염증(사구체신염)이 생기면 혈뇨와 단백뇨가 동시에 나타날 수 있습니다. 또한 신장암이 진행되면서 혈관이 파괴되면 눈에 보이는 혈뇨가 생깁니다.
『Kidney International』 연구에서는 육안적 혈뇨로 내원한 환자의 10% 이상에서 신장 질환이 원인으로 밝혀졌다고 보고했습니다. 따라서 혈뇨가 반복된다면 신장 초음파나 CT 검사가 필수적입니다.
5) 방광암 🚨




방광암은 혈뇨를 일으키는 대표적인 중증 원인입니다. 환자의 80% 이상에서 첫 증상으로 혈뇨가 나타난다는 보고가 있습니다. 통증이 없는 혈뇨, 즉 무증상 혈뇨일 경우 방광암 가능성을 반드시 고려해야 합니다.
『The Lancet Oncology』 학술지에 따르면, 50세 이상 남성이 통증 없는 혈뇨를 보일 경우 방광암 발견율이 매우 높다고 합니다. 따라서 고위험군이라면 정기적인 소변검사와 방광내시경 검진이 필요합니다.
6) 외상 및 운동 💥
교통사고, 낙상, 격한 운동 등으로 신장이나 방광에 충격을 받으면 혈뇨가 생길 수 있습니다. 마라톤, 축구처럼 장시간 강도 높은 운동 후 나타나는 일시적 혈뇨는 ‘운동성 혈뇨’라고 부르며, 보통 휴식을 취하면 사라집니다.
하지만 외상에 의한 혈뇨는 내출혈이나 장기 손상을 의미할 수 있어 반드시 병원 진료가 필요합니다. 특히 아이나 고령자에게서 외상 후 혈뇨가 발견되면 조기 검진이 매우 중요합니다.
7) 약물 및 항응고제 💊
혈액 응고를 억제하는 약물(와파린, 아스피린, 항응고제 등)을 복용하는 환자에게서 혈뇨가 나타나기도 합니다. 이 경우 소변 검사에서 적혈구가 발견되지만, 반드시 약물만이 원인이라고 단정할 수 없고, 다른 기저 질환을 배제해야 합니다.
『British Journal of Urology』 연구에서는 항응고제를 복용 중인 환자들의 20% 이상에서 현미경적 혈뇨가 확인되었다고 합니다. 따라서 약물 복용 중 혈뇨가 발생한다면 담당 의사와 상의해 용량 조절이나 추가 검진을 진행해야 합니다.
마무리 🌿
혈뇨는 단순히 “소변에 피가 섞인 현상”으로 끝나지 않습니다. 요로감염처럼 간단한 문제일 수도 있지만, 신장암·방광암 같은 심각한 질환의 초기 신호일 수도 있습니다. 따라서 혈뇨가 반복되거나 원인 없이 나타난다면 지체하지 말고 반드시 검사를 받아야 합니다.
특히 40세 이상 남성, 흡연자, 가족력 있는 분들은 정기 검진을 통해 혈뇨 원인을 조기에 확인하는 것이 필요합니다. 몸이 보내는 작은 신호를 놓치지 않는 것이 곧 건강을 지키는 가장 확실한 방법입니다. 🚨
건강공부는 건강저축
2025.09.27 - [건강] - 전립선비대증 증상 | 전립선 비대증이란 : 야간뇨 소변줄기 혈뇨
전립선비대증 증상 | 전립선 비대증이란 : 야간뇨 소변줄기 혈뇨
나이가 들수록 몸은 자연스레 변화를 맞이합니다. 머리카락이 희어지고, 근력이 줄어드는 것처럼 남성의 몸속 작은 기관인 전립선 역시 나이와 함께 변화를 겪습니다. 겉으로는 잘 드러나지 않
rich.ceonewmoon.com
2025.09.27 - [건강] - 전립선에 좋은 음식 | 전립선이란 : 토마토 석류
전립선에 좋은 음식 | 전립선이란 : 토마토 석류
남성에게 있어 전립선은 작지만 건강 전반에 큰 영향을 주는 기관입니다. 특히 중년 이후에는 전립선비대증, 전립선염, 전립선암 등 다양한 질환으로 이어질 가능성이 높아져 많은 분들이 고민
rich.ceonewmoon.com
2025.07.17 - [건강] - 파비플로라 효능 | 파비플로라란 : 질 건강 질염 방광염
파비플로라 효능 | 파비플로라란 : 질 건강 질염 방광염
장 건강에서 여성 건강까지, 섬세한 균형을 위한 선택 매일같이 피곤하고, 아랫배가 묵직한 느낌이 드는 날이 많아졌어요. 컨디션이 자주 흔들리고 피부도 푸석해질 때면 ‘혹시 내 몸의 균형이
rich.ceonewmoon.com
2025.08.08 - [건강] - 브로멜라인 효능 | 브로멜라인이란 : 부종 붓기 소화 항암
브로멜라인 효능 | 브로멜라인이란 : 부종 붓기 소화 항암
파인애플에서 온 놀라운 효소, 브로멜라인의 힘에 대해 알아보겠습니다. 며칠 전, 유난히 속이 더부룩하고 붓기가 빠지지 않아 천연 소화효소를 찾던 중 ‘브로멜라인’이라는 이름을 다시 마
rich.ceonewmoon.com
2025.07.19 - [건강] - 파비플로라 복용법 | 하루 권장량 (섭취량) | 복용 시간 | 파비플로라 복용기간 | 성분
파비플로라 복용법 | 하루 권장량 (섭취량) | 복용 시간 | 파비플로라 복용기간 | 성분
여성 유산균, 제대로 알고 섭취하세요 최근 질 건강과 장 건강을 동시에 케어하는 제품으로 각광받고 있는 파비플로라.여성 유익균 중심으로 설계된 기능성 유산균이지만, 효과를 제대로 보기
rich.ceonewmoon.com